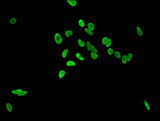

ChIP抗体
染色质免疫沉淀技术(Chromatin Immunoprecipitation,简称ChIP)是研究体内蛋白质与DNA相互作用的一种技术。它利用抗原抗体反应的特异性,可以真实地反映体内蛋白因子与基因组DNA结合的状况,用于信号传导和表观遗传学研究。
华美CUSABIO新推出的ChIP抗体经过ChIP、WB、IHC等多种应用验证,100%品质保证。同时,为您配套提供的试剂盒包含ChIP抗体及对照抗体Normal IgG、对应PCR引物。作为ChIP抗体生产商和验证者,我们库存充足,可保障发货速度。
ChIP级抗体来袭
表观遗传学研究者的福音
- ★ 抗体经过ChIP、WB、IHC等多种应用验证,提供验证数据,品质保证
- ★ 提供ChIP抗体及对照抗体Normal IgG、对应PCR引物
- ★ ChIP抗体生产商和验证者,国内现货,速度保障
| 抗体货号 | 蛋白靶点 | 种属反应性 | 应用 |
|---|---|---|---|
| CSB-PA010378OA45nme2HU | HIST1H1C | Human, Mouse, Rat | ELISA, WB, IHC, CHIP |
| CSB-PA010378OA45nme1HU | HIST1H1C | Human | ELISA, IHC, CHIP |
| CSB-PA010379OA85nbhbHU | HIST1H1D | Human | ELISA, IHC, CHIP |
| CSB-PA010429OA08nbhbHU | HIST1H4A | Human | ELISA, WB, IHC, CHIP |
| CSB-PA010418OA27nbutHU | HIST1H3A | Human, Mouse, Rat | ELISA, WB, IHC, IF, CHIP |
| CSB-PA010429OA79acHU | HIST1H4A | Human | ELISA, IHC, IF, CHIP |
| CSB-PA010418OA27acHU | HIST1H3A | Human, Mouse, Rat | ELISA, WB, IHC, IF, CHIP |
| CSB-PA010418OA37acHU | HIST1H3A | Human, Rat | ELISA, WB, IF, ChIP |
| CSB-PA010418OA23nbhbHU | HIST1H3A | Human | ELISA, IHC, CHIP |
| CSB-PA010403OA108acHU | HIST1H2BC | Human | ELISA, IHC, IF, CHIP |
| CSB-PA010403OA120nforHU | HIST1H2BC | Human, Rat | ELISA, WB, CHIP |
| CSB-PA010403OA14nphHU | HIST1H2BC | Human, Mouse, Rat | ELISA, WB, CHIP |
| CSB-PA010403OA12nme1HU | HIST1H2BC | Human, Mouse, Rat | ELISA, WB, CHIP |
| CSB-PA010403OA12me1HU | HIST1H2BC | Human, Mouse, Rat | ELISA, WB, IHC, CHIP |
| CSB-PA010429PA16acHU | HIST1H4A | Human | ELISA, ChIP |
| CSB-PA010389PA125crHU | HIST1H2AG | Human | ELISA, IF, ChIP |
| CSB-PA010389OA29me2HU | HIST1H2AG | Human | ELISA, ChIP |
| CSB-PA010389OA09nme1HU | HIST1H2AG | Human | ELISA, ChIP |
| CSB-PA010380OA145nphHU | HIST1H1E | Human | ELISA, ChIP |
| CSB-PA010378PA158crHU | HIST1H1C | Human | ELISA, IF, ChIP |